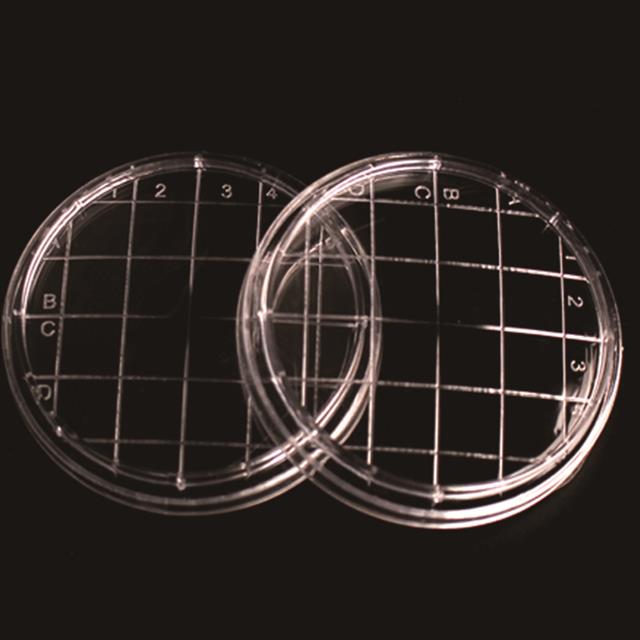

1.Four types of non-separation diameteravailable: 55, 75, 90 and 150mm
2.It can be used for bacterial culture.
3.The product is crystal clear and uniform in thickness.The bottom of the dish is smooth and free of distortion, which makes the quantitative analysis more accurate.
4.The strength of the cover and the bottom of the dish are enhanced, and the flatness is improved, so as to improve the adsorption of the inner wall of the dish.
5.The tooth ring design on the side of the dishfacil- itates holding and reducedcontamination.
6.The specially designed dish cover facilitates gas exchange.
7.The stacking rings make stacking and handling easier
8.There are γ-irradiation sterilization, DNase-free, RNase-free, and pyrogen-free products available for purchase.
| Name | Model | Specification | Height | Material | Sterilization method | Pcs/pack | Pcs/box |
| Bacterial culture dish | TW-150C | 150mm | 20mm | PS | EO | 10 | 110 |
| Bacterial culture dish | TW-90C | 90mm | 15mm | 500 | |||
| Floating bacterial culture dish | TW-75C | 75mm | 22mm | ||||
| Surface contact plate | TW-55C | 55mm | 15mm | 1000 |